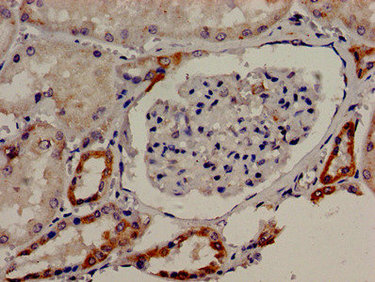
CSB-PA023218LA01HU

TBC1D4
TBC1D4,即TBC1域家族成員4,別名TBC1D4、RAB7L1等。它是一種由TBC1D4基因編碼的蛋白激酶,屬于TBC1域蛋白家族成員之一,在多種組織中表達(dá)。TBC1D4的作用機(jī)制涉及G蛋白信號(hào)傳導(dǎo)的調(diào)控,特別是通過(guò)其TBC結(jié)構(gòu)域?qū)ab GTP酶的活性進(jìn)行調(diào)節(jié),影響細(xì)胞內(nèi)囊泡運(yùn)輸和蛋白質(zhì)的細(xì)胞內(nèi)定位。TBC1D4參與了細(xì)胞內(nèi)多種生理過(guò)程,包括內(nèi)質(zhì)網(wǎng)到高爾基體的蛋白質(zhì)轉(zhuǎn)運(yùn)、細(xì)胞極性的建立、細(xì)胞遷移等。TBC1D4的功能異常與多種疾病有關(guān),如神經(jīng)退行性疾病、腫瘤等。研究表明,TBC1D4在腫瘤細(xì)胞中的異常表達(dá)可能與腫瘤的侵襲性和轉(zhuǎn)移性有關(guān),使其成為癌癥治療的潛在靶點(diǎn)。
熱銷(xiāo)產(chǎn)品
TBC1D4 Antibody (CSB-PA023218LA01HU)
驗(yàn)證數(shù)據(jù)

Immunohistochemistry analysis of human adrenal gland tissue using CSB-PA023218LA01HU at dilution of 1:100
Immunocytochemistry analysis of human kidney tissue using CSB-PA023218LA01HU at dilution of 1:100

Immunofluorescent analysis of Hela cells using CSB-PA023218LA01HU at dilution of 1:100 and Alexa Fluor 488-congugated AffiniPure Goat Anti-Rabbit IgG(H+L)
TBC1D4 Antibodies
TBC1D4 for Homo sapiens (Human)
| 產(chǎn)品貨號(hào) | 產(chǎn)品名稱 | 種屬反應(yīng)性 | 應(yīng)用類(lèi)型 |
|---|---|---|---|
| CSB-PA080083 | Phospho-TBC1D4 (T642) Antibody | Human,Mouse | WB, IHC, IF, ELISA |
| CSB-PA080084 | TBC1D4 Antibody | Human,Mouse | IHC, IF, ELISA |
| CSB-PA182529 | TBC1D4 Antibody | Human,Mouse | ELISA,WB,IHC |
| CSB-PA592036 | TBC1D4 Antibody | Human,Mouse | ELISA,IHC |
| CSB-PA023218LA01HU | TBC1D4 Antibody | Human | ELISA, IHC, IF |
| CSB-PA023218LB01HU | TBC1D4 Antibody, HRP conjugated | Human | ELISA |
| CSB-PA023218LC01HU | TBC1D4 Antibody, FITC conjugated | Human | |
| CSB-PA023218LD01HU | TBC1D4 Antibody, Biotin conjugated | Human | ELISA |
TBC1D4 Proteins
TBC1D4 Proteins for Homo sapiens (Human)
| 產(chǎn)品貨號(hào) | 產(chǎn)品名稱 | 來(lái)源 |
|---|---|---|
| CSB-YP023218HU CSB-EP023218HU CSB-BP023218HU CSB-MP023218HU CSB-EP023218HU-B |
Recombinant Human TBC1 domain family member 4 (TBC1D4), partial | Yeast E.coli Baculovirus Mammalian cell In Vivo Biotinylation in E.coli |












